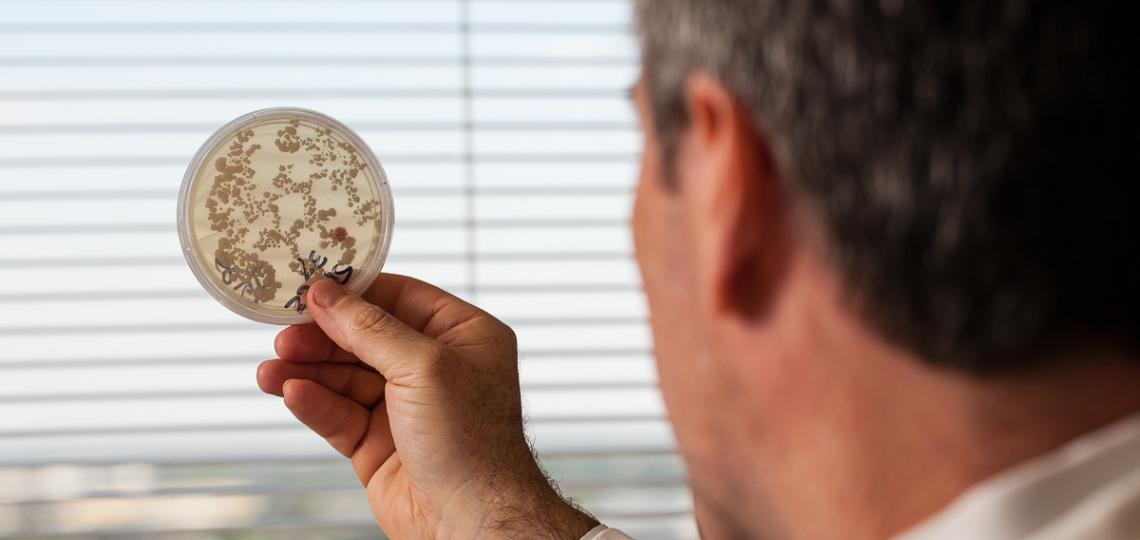
Fungus in Petri dish

Research is our passion! Medical care and research in the Section of Immunology, Allergy & Rheumatology is increasingly coordinated through specialty centers. These centers are able to more efficiently leverage the unique resources at Baylor College of Medicine to deliver a higher standard of care and research that are not available through the typical private practice and other academic medical centers. View a listing of our center researchers.
Our current and planned centers are as follows:
Biology of Inflammation Center
Founded in 2002, the BIC is a departmental research center that supports immunology-focused research and education and is generously funded through the Houston philanthropic community.
IAR Research Endowments
Our seven endowed research programs:
- Cullen Chair in Immunology
- The Mendenhall Asthma Research Program
- Trammell Chair in Allergy
- Finger Lupus Center
- Brochstein Arthritis Research Program
- Papadopoulos Autoimmunity Research Program
- Kostas Dermatomyositis Research Program
Basic and Clinical Science Research
- Autoimmune lung and skin fibrosis
- Fibroblast-macrophage interactions
- Cadherin biology
- Use of virtual tools for patient and provider education in autoimmune diseases
- Registry of COVID-19 infections in autoimmune disease
- Allergic disease pathogenesis
- Fungi and antifungal immunity
- MicroRNA-based control of immunity
- Inflammatory bowel disease
- Alzheimer’s disease
- Asthma
- Chronic sinusitis
- Fungal allergies
Grace Hsiao-Wei Lo, M.D., M.S.
- Identifying risk factors (including cardiovascular risk factors, genetic risk factors, biomechanical risk factors and exposure to physical activity) for the development and progression of osteoarthritis
- Understanding the clinical implications of findings on imaging in osteoarthritis
- Improving outcome measures in osteoarthritis, including clinical and imaging measures
- Clinical trials in osteoarthritis
- Primary Sjogren's syndrome
- Systemic lupus erythematosus-epidemiology and clinical trials
- Lung inflammation: understanding how let-7 microRNA orchestrates immune cell and epithelial response to lung injury
- Health Disparities and Comparative Effectiveness Research
- Rheumatic Diseases, including Gout, Osteoarthritis, Lupus, Rheumatoid Arthritis and total joint replacement
- Elucidating the molecular mechanisms of innate and allergic airway inflammation and dissecting the mechanisms of associated chronic neurologic inflammation that contributes to Alzheimer's disease
- Examining how DNA damage, repair, recognition and cross-talk with immune recognition of cytosolic and nuclear DNA together modulate innate immune responses and contribute to pathways that either induce or regulate innate chronic allergic airway inflammation and chronic brain inflammation
- Determination of novel genetic causes of autoimmune and immune dysregulatory disorders
- Investigation of unique biomarkers and therapeutic targets in pediatric autoimmunity
- Advancement of the understanding of cytokine signals in health and in autoimmune disease
Projects and Funding Support
Eli Lilly and Co: Validation of novel ixekizumab impacted signaling pathways through meta-analysis of transcriptomic datasets
The major goal is to use microarray expression profiling to determine the role of IL-17 in psoriasis.
PCORI (Patient Centered Outcomes Research Institute): Implementing Decision Aid for Lupus - IDEAL STRATEGY
Multi-center quality improvement trial in collaboration with the University of Alabama to implement an individualized decision aid model with lupus kidney disease to learn about their illness and therapeutic options.
NIH R01: Fungal Pathogenesis of Moderate to Severe Asthma
The major goal is to define the mechanisms by which fungi lead to asthma-like disease, combining mouse and human studies.
NIH R01: Mechanism and Function of Let-7, a Novel Modulator of Th17-dependent Emphysema
The major goal is to define the mechanism by which let-7 microRNAs regulate Th17 responses in smoking and carbon black-dependent emphysema.
NIH R01 Supplement: Fungal Pathogenesis of Chronic Brain Disease
The major goal is to define the mechanism by which the yeast Candida albicans crosses the blood-brain barrier to enter the brain to produce Alzheimer’s Disease-like pathology and develop an anti-Candida vaccine that prevents brain invasion.
Department of Veterans Affairs (VAORD): Molecular and Cellular Dissection of miRNAs in Controlling Allergic Airway Inflammation in Mice
The major goal is to dissect microRNA (miRNA)-dependent inflammatory pathways in dendritic cells (DCs) and CD4+ T cells that modulate murine allergic airway disease.
NIH R01 Supplement: Pathogenesis of Polymicrobial Cerebritis-related Dementia
The major goal is to understand how the yeast Candida albicans travels from the gut to the brain to induce Alzheimer’s-like disease.
NIH R01 Supplement: IMPACC-MEDVAMC – COVID-19 Study
The major goal is to understand how the yeast Candida albicans travels from the gut to the brain to induce Alzheimer’s.
Grace Hsiao-Wei Lo, M.D., M.S.
NIH/NIAMS R21: A Pilot Randomized, Controlled Trial of Hand Osteoarthritis
The major goal is to propose a randomized, controlled clinical trial evaluating whether hand traction will treat symptoms and structural progression in hand osteoarthritis.
Novartis Pharmaceuticals: A Randomized, Double-blind Placebo Controlled Multicenter Phase 2 Dose-ranging Study to Assess the Safety and Efficacy of Multiple VAY736 Doses Administered Subcutaneously in Patients with Moderate to Severe Primary Sjögren’s Syndrome
This trial is closed, and we are looking to recruit patients with primary Sjogren’s for a phase 3 extension, looking at long-term safety of a drug that has shown some efficacy in an earlier study to help symptoms of Sjogren’s.
Novartis Pharmaceuticals: Clinical trial CFZ533B2201/Ianumumab-Multicenter: A 48-week Four-arm Double-blind Study for Two Cohorts of Primary Sjogren’s Syndrome
The major goal is to evaluate a new immunomodulatory agent for efficacy in two groups of patients – one set with mostly dryness in the eyes and mouth, and the other set with organ involvement. Treatment for primary Sjogren’s syndrome is currently limited at this time to symptomatic therapy. The role of immunosuppression in disease progression is not clearly defined, and newer immune targets are being evaluated.
Gillson-Longenbaugh Foundation: Role of Let-7 microRNA in Chronic Obstructive Pulmonary Disease
The major goal of this study is to characterize a novel genetic risk factor for emphysema and enable targeted prevention efforts for at-risk individuals in the population.
NIH R01 Supplement: Role of Let-7 as Genetic Modifier of Alzheimer’s Disease
The goal of this project is to determine if let-7 can alter Alzheimer’s disease severity elicited in the murine model Tg 5xFAD.
Department of Veterans Affairs (VAORD): Molecular and Cellular Dissection of miRNAs in Controlling Allergic Airway Inflammation in Mice
The major goal is to dissect microRNA (miRNA)-dependent inflammatory pathways in dendritic cells (DCs) and CD4+ T cells that modulate murine allergic airway disease.
NIH R01: Mechanism and Function of Let-7, a Novel Modulator of Th17-dependent Emphysema
The major goal is to define the mechanism by which let-7 microRNAs regulate Th17 responses in smoking and carbon black-dependent emphysema.
NIH R01: Role of Cytosolic DNA-multiprotein Interactome in Allergic Airway Inflammation
The major goal is to test the central hypothesis that allergic humans and mice develop an allergosome in the cytoplasm of the airway mucosa and lungs that stimulates allergic airway inflammation.
Department of Defense (DOD): Role of Cytosolic DNA Sensor in Allergic Airway Inflammation
The major goal is to test the hypothesis that allergic mice and humans develop [remove line break] a DNA-protein complex in the airway epithelium that provides a stable, efficient signaling platform to generate IRF3 and stimulate AIR.
NIH R01 Supplement: Allergic Lung Inflammation-induced Oxidated DNA Damage in the Brain as a Risk Factor for Alzheimer’s Disease
The major goal is to evaluate lung inflammation
NIH U01: BCM Clinical Site for an Undiagnosed Diseases Network (UDN)
The major goal is to provide answers to patients with mysterious conditions that have eluded diagnosis and to advance medical knowledge about rare and common diseases.
Rheumatology Research Foundation Medical Student Preceptorship: Crossing the BRIDGE: Transfer & Outcomes (Vogel)
The major goal is to support quality improvement efforts in rheumatology transition medicine.
CHEST Foundation: COPA Syndrome-associated Mutations in Lung Transplant Recipients for Pulmonary Fibrosis
The major goals of this project are to screen the DNA from explants of patients who had lung transplants for pulmonary fibrosis, looking for mutations in COPA to diagnose COPA syndrome.
NIH R01: Endothelial-to-osteoblast Conversion in Prostate Cancer Bone Metastasis
The major goals are to: Determine the mechanisms underlying endothelial cell-to-osteoblast (EC-OSB) transition. Identify EC-OSB hybrid cell secreted factors (EC-OSB factors) that promote PCa progression. Develop strategies that target EC-OSB hybrid cells to improve therapy outcomes for PCa bone metastasis. Determine whether EC-OSB transition occurs in normal bone and the fraction of EC-OSB hybrid cells in tumor-induced bone.
Cancer Prevention and Research Institute [remove line break] of Texas (CPRIT): Regulation of Dormancy of Metastatic Prostate Cancer Cells by Bone Microenvironment
The goals are to determine the effects of RARg agonists on EC-to-OSB conversion, on inhibiting osteoblastic bone lesions in animal models, in combination with bone targeting therapies on PCa tumor growth in vivo, and the mechanism of RARg agonist inhibition of EC-to-OSB transition.